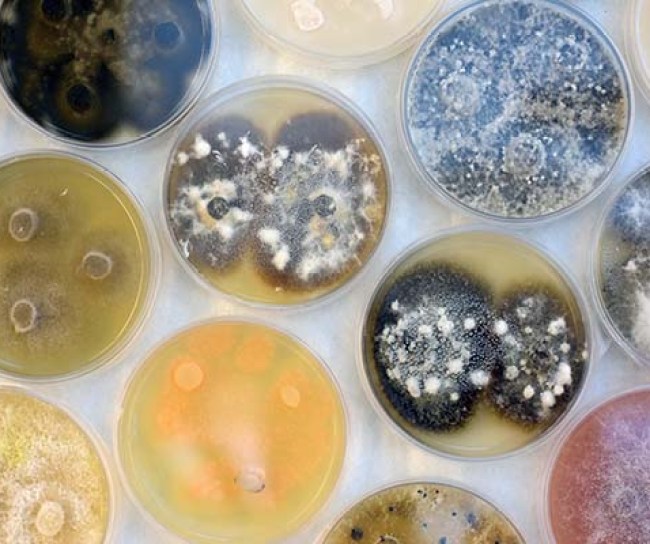

Acceso a la salud
En MSD creemos que tenemos un importante papel y responsabilidad en la mejora del acceso a medicamentos, vacunas y atención médica de calidad en todo el mundo, ayudando así a reducir la carga de la enfermedad en los países que más lo necesitan.
MSD en España
Fundación Medina
Es un centro de referencia a nivel mundial en el descubrimiento de nuevos fármacos a partir de productos naturales de origen microbiano y uno de los centros de cribado de alta capacidad de la nueva red europea EU-OPENSCREEN-ERIC, reconocida en marzo de 2018 por la Comisión Europea como Infraestructura de Investigación Europea (ERIC).
En la actualidad, y gracias a la cesión que realizó en mayo de 2017 MSD de su colección de cultivos microbianos, la Fundación MEDINA se ha convertido en la institución con la mayor librería de cultivos microbianos del mundo en una única sede. La colección de MSD cedida a MEDINA comprendía más de 74.000 cultivos microbianos (hongos y bacterias) de una amplia diversidad de orígenes geográficos y ecosistemas, incrementando los recursos de MEDINA hasta alcanzar los 190.000 cultivos.

Apoyo a asociaciones de pacientes y otras organizaciones
MSD mantiene un compromiso desde hace más de 20 años con las organizaciones de pacientes que desarrollan una labor sociosanitaria en defensa de los pacientes, sus cuidadores y allegados.
MSD a nivel global

Diversidad e inclusión
Fomentar la inclusión, crear un sentido de pertenencia a los equipos y promover la diversidad en todas sus dimensiones, genera innovación.
Sabemos que la diversidad, equidad e inclusión son fundamentales para nuestro éxito y para la innovación futura. Fomentamos una cultura de inclusión y pertenencia donde todos los empleados se sientan bienvenidos y valorados. Consideramos que cada individuo aporta una ventaja competitiva a nuestra misión más amplia de salvar y mejorar las vidas de las personas.
Con esta estrategia defendemos la diversidad y la inclusión como valores fundamentales y esenciales para cada aspecto de nuestro negocio, lo que nos permite innovar, ejecutar, adaptarnos y crecer. A su vez, esto aporta un valor intrínseco a largo plazo a nuestros pacientes, empleados, clientes y accionistas.
Programas de RSC

Programa MSD para las Madres
Esta es una campaña a largo plazo y a escala global, con más de 15 años de recorrido, con una inversión de 650 millones de dólares, con el objetivo de reducir las muertes relacionadas con el embarazo y el parto. Hasta la fecha, más de 39 millones de mujeres a nivel mundial se han beneficiado de las mejoras en el acceso a la atención de la salud materna. Se han llevado a cabo 295 programas, con la colaboración de más de 200 partners en 75 países de los cinco continentes.
Además, MSD para las Madres, colabora con otras iniciativas centradas en la salud maternal, como la Sexta Ronda de Subvenciones Globales de MSD, centrada en la mejora de la Salud Materna en América Latina, apoyando a organizaciones en Brasil, Colombia, República Dominicana, Ecuador y México, con el objetivo de llegar a más de 135.000 mujeres.

Proyecto de donación MECTIZAN®
Gracias a este programa, por el que MSD dona íntegramente el fármaco MECTIZAN® (ivermectina) desde hace casi 40 años, Colombia, Ecuador, Guatemala y México han recibido la verificación de eliminación de la oncocercosis o ceguera de los ríos por parte de la Organización Mundial de la Salud (OMS).
Este programa dona cada año más de 150 millones de tratamientos para la oncocercosis y 133 millones para la filariasis linfática, y lo seguirá haciendo mientras se necesite.
MSD decidió que el Programa de Donación MECTIZAN® se ampliase a partir de 2018 con el objetivo de llegar a otros 100 millones de personas por año hasta 2025, como parte del esfuerzo global para eliminar también la filariasis linfática (FL) o elefantiasis. Ese año, celebramos que habíamos llegado a los 5 mil millones de tratamientos donados

Programa MSD Gives Back de Voluntariado
Para promover el espíritu solidario de manera individual, MSD cuenta con el Programa de Voluntariado Corporativo, por el que cada empleado dispone de 40 horas al año dentro del horario laboral para realizar actividades solidarias. Esta iniciativa está enmarcada en el programa global llamado “MSD Gives Back”, por el que cada año miles de empleados se ofrecen voluntariamente para colaborar en su entorno. En 2019 los empleados registraron en la plataforma MSD Gives Back más de 136.000 horas de voluntariado en todo el mundo.

Programa Fellowship for Global Health
El Fellowship for Global Health es un programa de voluntariado de tres meses que brinda a nuestros empleados la oportunidad de aplicar sus talentos y experiencia en todo el mundo. Los empleados elegidos para este programa se denominan becarios Richard T. Clark (RTC) en honor a nuestro ex director ejecutivo Dick Clark. El programa combina la experiencia de nuestros empleados con organizaciones sin fines de lucro de todo el mundo para mejorar de manera significativa y sistemática la atención médica para las personas que más la necesitan.








